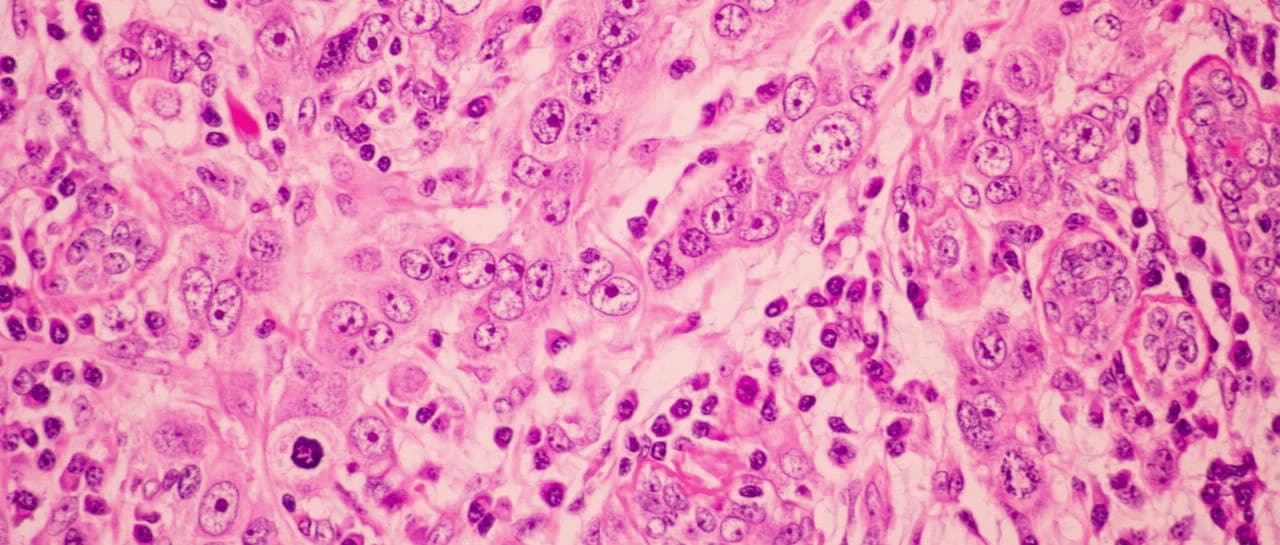

新たな評価手法(NAMs)
米国 FDA などの世界中の規制機関は、科学的に検証された新たな評価手法(NAMs)を用いて、前臨床安全性試験における動物実験の削減を目指しています。NAMs には、人類生物学に高い関連性を持つ毒性を評価できる in vitro プラットフォームが含まれており、動物の使用を削減しながら、より迅速かつ正確にリスクを評価できる可能性があります。
アジレントの in vitro アッセイ、3D 細胞培養分析、細胞ベースのハイスループットスクリーニングソリューションを使用することにより、薬物毒性を高い信頼性で調査して、安全性を予測することができます。